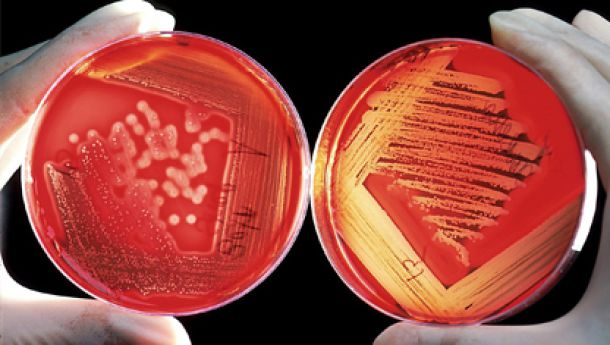

Blog/News
Blog
Auf dieser Seite findest du Artikel zu verschiedenen Themen aus dem Bereich der Tiergesundheit. Zusätzlich werden hier unsere Newsletter veröffentlicht.
Du möchtest selbst Autor/Autorin werden und hier veröffentlichen? Sprich uns an!
WhatsApp-Kanal
Abonniere unseren WhatsApp-Kanal!
Neuigkeiten, Tipps und Infos rund um Tiergesundheit, Naturheilkunde und unsere Kurse 🐴🐶🐱
Bleib auf dem Laufenden und verpasse keine Termine mehr!